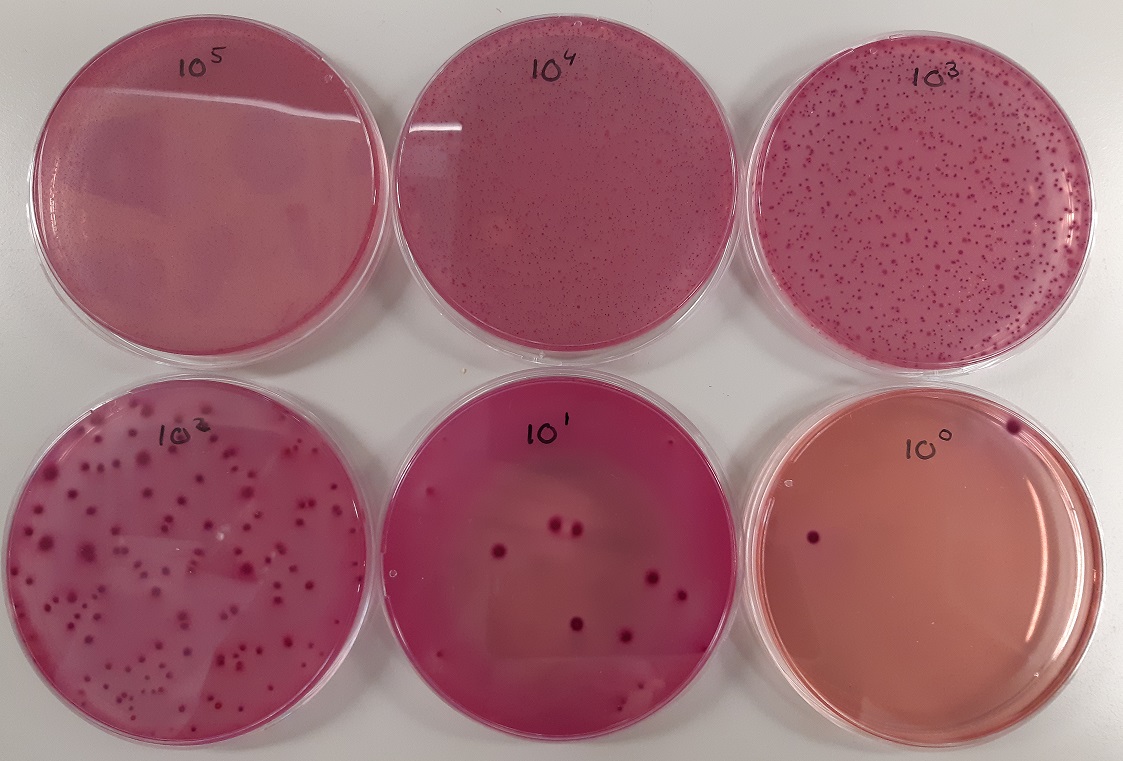

Verkennen
Bacteriën groeien exponentieel door zichzelf steeds te delen. Daardoor kan uit één bacteriecel een zichtbaar hoopje bacteriën ontstaan. Dit heet een bacteriekolonie en de bacteriecel waaruit hij ontstaat heet een kolonievormende eenheid (KVE).
In zes petrischaaltjes zijn voedingsbodems gemaakt waarop bacteriecellen kunnen groeien. Op deze voedingsbodems is
`1`
mL verdund monster met bacteriecellen aangebracht, de verdunningsfactor is op iedere voedingsbodem verschillend. Hoe meer verdund, hoe minder bacteriekolonies er ontstaan. Zie onderstaande afbeelding.
Bekijk de voedingsbodem waarbij het monster
`10^2`
keer is verdund, omdat het aantal kolonies daarop goed is te tellen. Bij het ontstaan van de kolonies groeit het aantal bacteriën in een kolonie exponentieel. Voor de exponentiële groei van aantal bacteriën geldt daarin
`B = 8^t`
waarin
`B`
het aantal bacteriën is en
`t`
de tijd in uren.
Na hoeveel uur (in minuten nauwkeurig) is het aantal bacteriën in een kolonie uitgegroeid tot `6000` ?